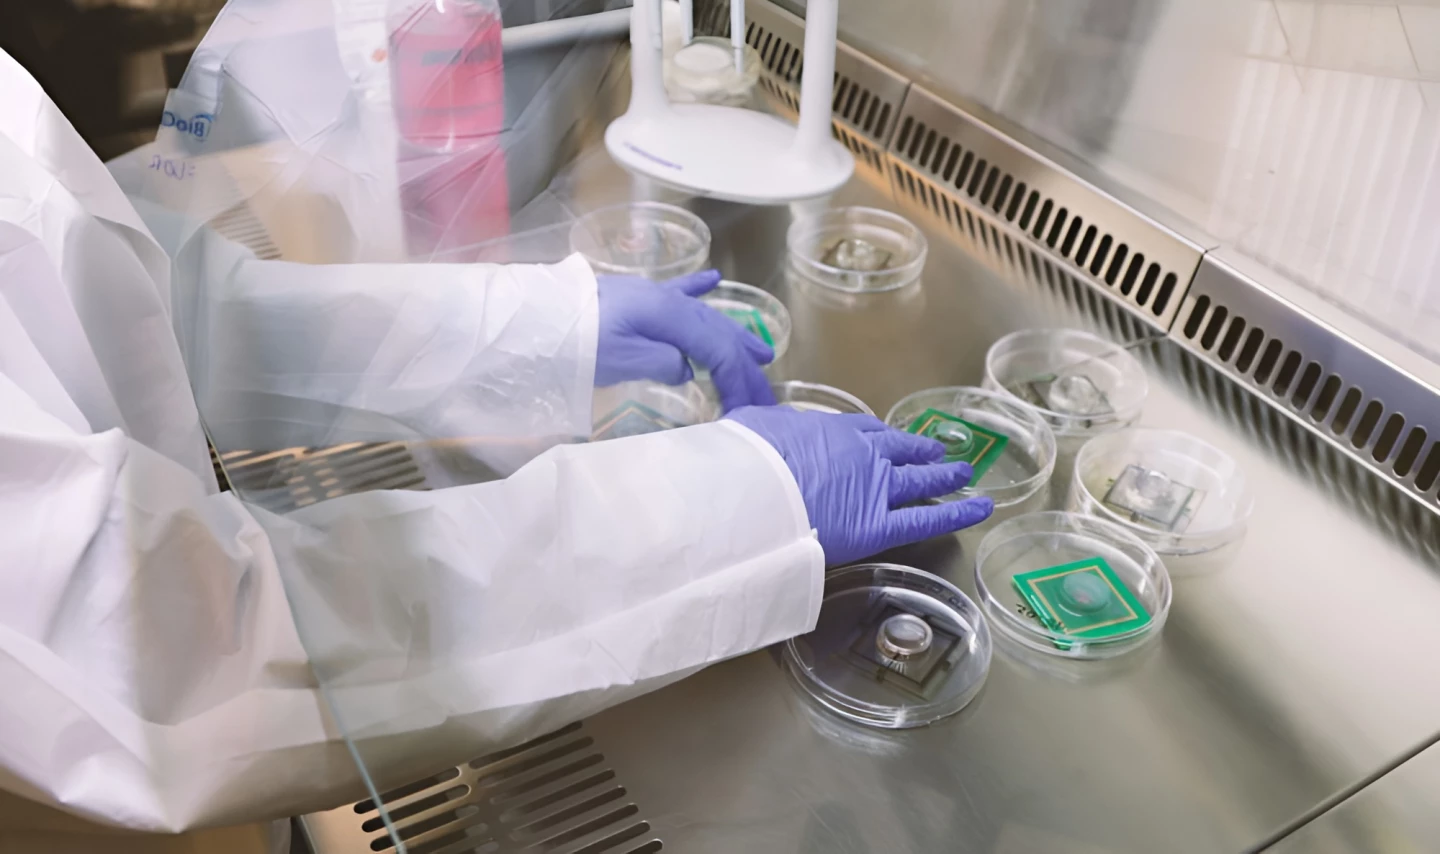

Current AI training methods burn colossal amounts of energy to learn, but the human brain sips just 20 W. Swiss startup FinalSpark is now selling access to cyborg biocomputers, running up to four living human brain organoids wired into silicon chips.
The human brain communicates within itself and with the rest of the body mainly through electrical signals; sights, sounds and sensations are all converted into electrical pulses before our brains can perceive them. This makes brain tissue highly compatible with silicon chips, at least for as long as you can keep it alive.
For FinalSpark's Neuroplatform, brain organoids comprising about 10,000 living neurons are grown from stem cells. These little balls, about 0.5 mm (0.02 in) in diameter, are kept in incubators at around body temperature, supplied with water and nutrients and protected from bacterial or viral contamination, and they're wired into an electrical circuit with a series of tiny electrodes.

These two-way electrodes can send pulses of electricity into the brain organoids, and they can also measure the responses coming out of them. And that's really all you need to start taking advantage of nature's greatest computing machines; neurons habitually search for patterns, seeking order and predictability.
You can create a virtual environment for them, complete with the capability to perform actions and perceive the results, solely using electrical stimulation. You can reward them with predictable stimuli and 'punish' them with chaotic stimuli, and watch how quickly they rewire themselves to become adept at orienting themselves toward those rewards.
We've written before about computer chips with integrated brain cells – notably the Australian DishBrain device by Cortical Labs, which uses 800,000 human brain cells grown onto silicon chips. DishBrain managed to learn to play Pong within about five minutes, and has demonstrated impressive capabilities as a super-efficient machine learning tool, even drawing in military funding for further research.
The FinalSpark team uses smaller organoids, wired into arrays, and it also adds a new wrinkle, in the ability to flood the organoids with reward hormones like dopamine when they've done a good job.
"We encapsulate dopamine in a molecular cage, invisible to the organoid initially," co-founder Dr Fred Jordan told Techopedia last year. "When we want to ‘reward’ the organoid, we expose it to specific light frequencies. This light opens the cage, releasing the dopamine and providing the intended stimulus to the organoid."
It's an absolutely bizarre frontier of research, and it certainly makes some people uncomfortable. But Jordan points out that humans have long harnessed living things to do work, be it the yeast that brews our beer or the horses that pulled ploughs through our fields.

Are these things sentient? Nobody really knows – and for a deep dive into the thorny ethics of this whole 'wetware computing' field, you should definitely check out our extensive interview with Brett Kagan of Cortical Labs, who has to wrestle with some pretty wild philosophical questions in his daily work.
But they could definitely prove useful – both as ultra-efficient cyborg machine learning platforms, and also as remarkable new tools to test the effects of various drugs on the brain's information processing capabilities.
FinalSpark's Neuroplatform places wetware biocomputing into a cloud-accessible format, allowing researchers and commercial users the ability to buy time with the brain chips, along with Python-based software with which to interact with the devices. The company will keep the brain organoids alive and healthy as long as possible, and you can give them things to do.
It's a very nascent area; GPT-5 will certainly not be trained using human brain cells. But these natural computers are so incredibly efficient – up to a billion times more energy-efficient than silicon chips – that FinalSpark believes they may yet play a role in mitigating climate change.
Current neural computers guzzle so much energy training large AI models that Elon Musk, among others, has predicted we'll soon be experiencing energy shortages around data processing centers. If cyborg biocomputers could radically reduce that energy consumption, they could certainly make a contribution – but they're a long way off scaling to the size of a single GPU, let alone the multi-billion-dollar clusters the AI giants are amassing.
I'll confess, FinalSpark's business name does send a bit of a chill down my spine. Forgive my wild, dystopian speculation here, but maybe there's a chance that silicon never manages to outstrip living cells in learning efficiency. Maybe these wetware bio-chips do scale advantageously. And maybe, when humanity is long gone, human brain cells might still prove useful to our AI descendents, a 'final spark' of biological life that might move forth into the cold emptiness of the galaxy without us.
Source: FinalSpark